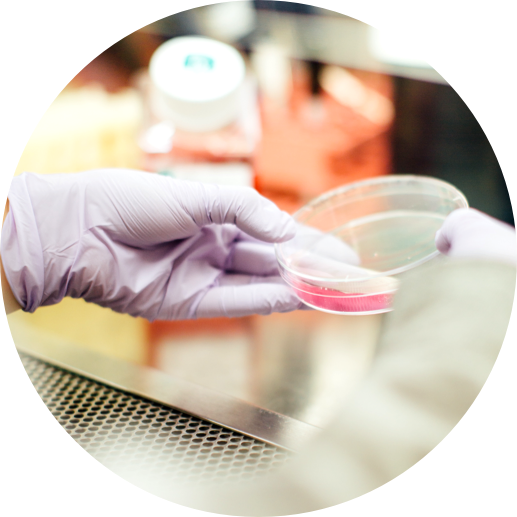

Newborn Screening Resources
The NewSTEPs resource library incorporates all archived resources on the NewSTEPs website, which can be filtered below by disorder, type and topic.
Trending Data Visualizations
View trending interactive data dashboards that utilize data entered into the NewSTEPs Data Repository including state profile data, monthly and annual quality indicator data, and case data.